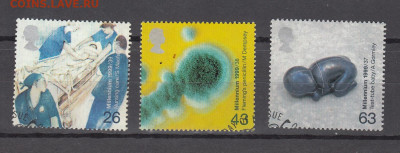
Великобритания 1999 3м (3)до 30 09 - 42

| Текущее время: 25-11-2025 22:16:53 |
|
|
Список форумов » ТОРГОВЫЕ РЯДЫ » Архивы » Аукционы Часовой пояс: UTC + 3 часа |
| Страница 1 из 1 |
[ Сообщений: 2 ] |
Фильтр
|
|
| Автор | Сообщение | ||
|---|---|---|---|
|
|
|
||
|
Зарегистрирован: 17-02-2011 11:56:17 Сообщения: 166870 Город: Новосибирск Пол: Благодарил (а): 0 раз. Поблагодарили: 60,00 Lv (15 раз.) Имя: SERG 1966 |
|||
| Вернуться к началу |
|
||
|
|
|
||
|
Зарегистрирован: 17-02-2011 11:56:17 Сообщения: 166870 Город: Новосибирск Пол: Благодарил (а): 0 раз. Поблагодарили: 60,00 Lv (15 раз.) Имя: SERG 1966 |
|
||
| Вернуться к началу |
|
||
| Лот закрыт: 01-10-2020 08:14:18. Сумма закрытия: 0,00 Lv |
| Страница 1 из 1 |
[ Сообщений: 2 ] |
|
Список форумов » ТОРГОВЫЕ РЯДЫ » Архивы » Аукционы Часовой пояс: UTC + 3 часа |
Кто сейчас на конференции |
Сейчас этот форум просматривают: Applebot [Bot], ClaudeBot [Bot], coins2000, Semrush [Bot] и гости: 9 |
| Вы не можете начинать темы Вы не можете отвечать на сообщения Вы не можете редактировать свои сообщения Вы не можете удалять свои сообщения Вы не можете добавлять вложения |
⇧
⇩